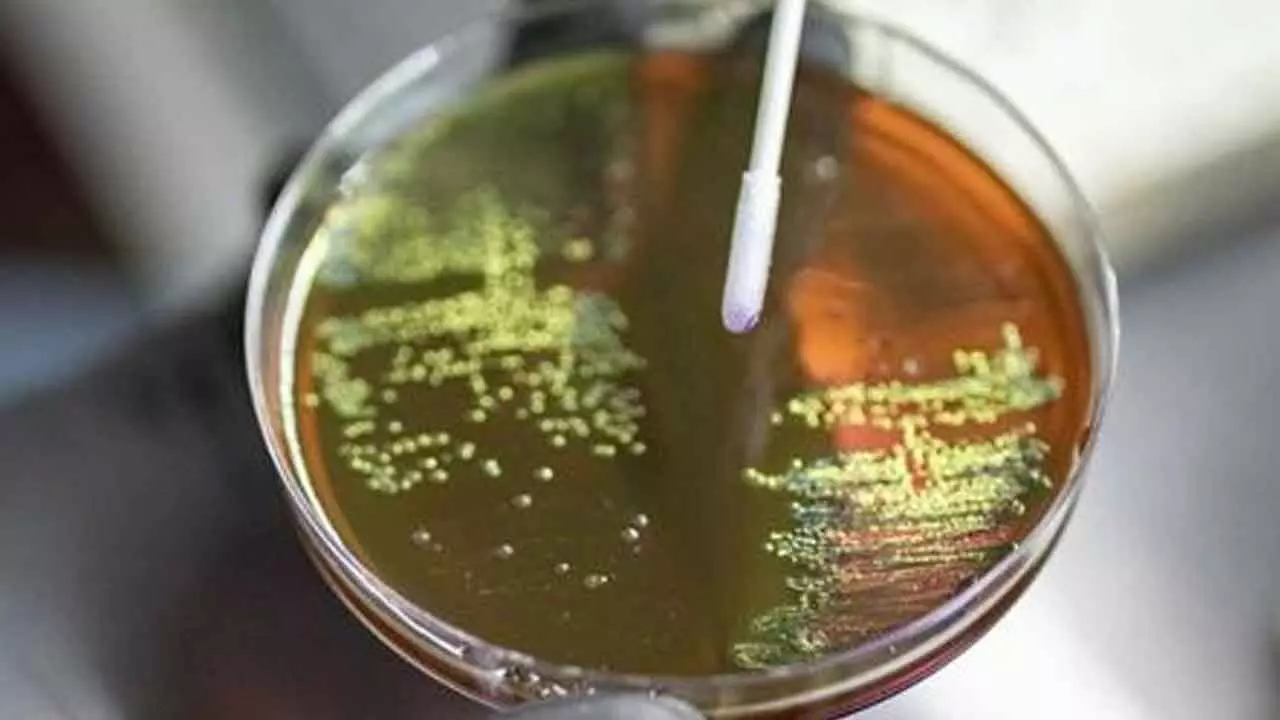

India at epicentre of superbug surge as antibiotic resistance reaches alarming levels
Experts caution that everyday healthcare in India is already struggling against wide-spread antibiotic resistance
India at epicentre of superbug surge as antibiotic resistance reaches alarming levels
Antimicrobial Resistance (AMR) has emerged as an immediate public health crisis in In-dia, with experts warning that infections once easily treatable are now becoming dangerously dif-ficult to manage.
Florian von Groote of the Wellcome Trust highlights that India faces some of the highest rates of drug-resistant bacterial infections globally, driven by widespread antibiotic misuse and gaps in infection control.
WHO and Lancet data show soaring resistance in key path-ogens, while national surveillance underscores shrinking treatment options. With India identified as a global hotspot, experts urge responsible antibiotic use, stronger surveillance and accelerated development of new medicines, vaccines and diagnostics.
New Delhi: Resistance (2025-29) with Antimicrobial Resistance (AMR) is not just a threat for the future, but a present reality affecting millions of people across the globe, particularly India, said Florian von Groote, Head of Clinical Research, at Wellcome Trust Infectious Disease Clinical Research Team, UK, on Monday.
Speaking to IANS, von Groote, an infectious disease expert, shared that AMR is one of the top global health issues causing millions of infections and deaths each year. India, with its large pop-ulation, high infectious disease burden, and widespread antibiotic use, remains disproportionally affected.
“AMR is no longer a hospital-only issue but rather affects every day healthcare in India. These trends reflect widespread antibiotic misuse, gaps in infection control, and poor surveillance in many parts of the country. AMR is not a future threat but rather a present reality in India,” he said.
India continues to face some of the world’s highest burdens of bacterial infections.
According to a recent World Health Organization (WHO) report, about one in three bacterial in-fections in India were resistant to commonly used antibiotics in 2023. Globally, it was one in six confirmed infections.
National AMR surveillance data also show troubling resistance patterns in pathogens such as E. coli, Klebsiella pneumoniae, Staphylococcus aureus, and Acinetobacter baumannii.
A recent study, published in the Lancet eClinical Medicine journal, warned that India is at the epicentre of a superbug explosion as several patients in the country were found to carry multiple highly resistant organisms simultaneously.
It showed that more than 80 per cent of Indian patients carry multidrug-resistant organisms (MDROs) -- the highest globally.
von Groote noted that attention to AMR is rising because common infections are becoming hard-er to treat, antibiotics are failing, and the economic impact can no longer be ignored.
“Resistance levels to certain key antibiotics are indeed alarmingly high. Therapeutic options are shrinking, and many first-line and even last-line antimicrobials are losing effectiveness, resulting in previously easily manageable infections being difficult or impossible to treat,” von Groote told IANS.
“India carries one of the heaviest antimicrobial resistance burdens in the world. In 2019, the country saw an estimated 267,000 deaths directly caused by drug-resistant infections, placing it among the highest contributors to global AMR deaths," the infectious disease expert added, cit-ing data from joint research from Oxford University, UK, and the University of Washington, US.
While ICMR’s latest data indicate a modest improvement in E. coli susceptibility to ceftazidime (from 19.2 per cent in 2023 to 27.5 per cent in 2024), rising resistance to carbapenems and col-istin remains a red flag, signalling diminishing treatment options in the country.
"Compared with other populous countries in Asia and Africa, India remains a critical hotspot... due to sheer size, high infection load, and widespread antibiotic misuse," von Groote said.
Notably, to contain antibiotic resistance, the Ministry of Health and Family Welfare launched the second version of the National Action Plan on Antimicrobial key strategies.
The NAP-AMR 2.0 addresses the gaps identified in the first NAP-AMR by increasing the own-ership of AMR-related efforts, strengthening intersectoral coordination, and ensuring stronger engagement with the private sector through a One Health approach.
Meanwhile, von Groote suggested rational and responsible use of antibiotics; better surveillance across humans, animals, and the environment; and a push to develop novel drugs, vaccines, and diagnostics.
The expert also mentioned simple measures such as hand hygiene and other infection control practices to reduce the need for antibiotics.
(The writer is a special correspondent with an international news agency)

